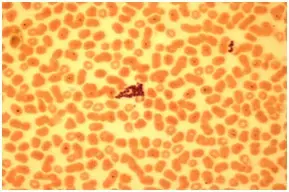

Урок-практикум "Особенности строения растительной и животной клетки". 6-й класс
Цель: расширить знания о строении эукариотической клетки растений и животных.
Задачи:
-
Развивающие:
- уметь выявлять особенности растительной клетки по сравнению с животной клеткой;
- уметь делать выводы о морфологических особенностях , о единстве строения и происхождения клетки.
-
Образовательные:
- показать многообразие форм клеток;
- рассмотреть строение растительной и животной клеток под микроскопом.
- Воспитательные: воспитывать интерес к познанию живой природы.
Оборудование: микроскоп, набор предметных и покровных стекол, препаровальные иглы, пинцеты , пипетки, пузырек с чистой водой, пузырек со слабым раствором йода. ), луковица, готовый микропрепарат «Кожица лука», готовые микропрепараты костной и мышечной ткани, мазки крови лягушки и человека.
ХОД УРОКА
1. Актуализация знаний
- Ребята, наш урок я хочу начать со стихотворения.
Клетка - жизни всей основа!
Повторять мы будем снова!
Только есть одна беда:
Не удастся никогда
Нам увидеть клетку глазом.
А хотелось бы всё сразу
Рассмотреть и разобрать,
Клетки перерисовать!
Ведь из клетки состоят:
Морж, медведь, петух и кит.
Дуб, сосна, собака, кошка,
Да и гриб на тонкой ножке!
Многоклеточные мы:
И поэтому должны
Клетки мышц мы упражнять,
Клетки мозга развивать.
Обеспечат эти клетки
Нам хорошие отметки!
Вопросы:
- Из каких структур состоят организмы растений и животных? (Из клеток).
- Как называется наука изучающая клетку? (Цитология)
- Сегодня мы познакомимся с особенностями строения клеток растений и животных.
2. Изучение нового материала
Теоретическое введение
Для знакомства с клетками и изучения их строения используют увеличительные приборы - микроскоп и различные лупы. С предыдущих занятий обучающиеся 6 класса имеют представление об увеличительных
приборах. Они знают, что под лупой можно рассматривать части растений непосредственно, без всякой обработки. Чтобы рассмотреть что-либо под микроскопом, нужно приготовить временный или
воспользоваться готовым микропрепаратом.
Для приготовления временного микропрепарата объект помещают на предметное стекло. Для лучшей видимости и сохранности его кладут в каплю воды и покрывают сверху очень тонким покровным стеклом. Такой
препарат называют временным, после работы его можно смыть со стекла. Но можно сделать и постоянный препарат, который будет служить многие годы. Постоянные микропрепараты изготавливают в специальных
лабораториях. Для этого объект заключают не в воду, а в специальное прозрачное смолистое вещество, которое быстро затвердевает, прочно склеивая предметное и покровное стёкла. Для лучшей различимости
деталей строения объекта микропрепараты окрашивают специальными красителями. Так получают постоянные окрашенные микропрепараты.
Микроскоп же позволяет рассматривать и изучать объекты при большом увеличении. Убедимся в этом в ходе лабораторной работы
Постоянный микропрепарат «Кожица лука» окрашен сиреневым красителем. Кожица, покрывающая чешую лука, состоит из одного слоя клеток, плотно прилегающих друг к другу. Клетки имеют вытянутую или
многоугольную форму, покрыты тонкой оболочкой с порами. Ядро обычно находится в середине клетки. Оно окрашено в лиловый цвет. В ядре видны одно-два тёмных ядрышка. Цитоплазма тонким слоем примыкает к
оболочке. Иногда в клетке видны вакуоли, заполненные клеточным соком.
Правила работы с микроскопом:
- Поставьте микроскоп штативов к себе на расстоянии 5-10 см от края стола.
- В отверстие предметного столика направьте свет.
- Работу с микроскопом всегда начинать с малого увеличения.
- Опустить объектив в рабочее положение, т.е. на расстояние 1см от предметного стекла.
- Поместите на предметный столик микропрепарат так, что бы изучаемый объект находился под объективом и зафиксируйте его клеммами.
- Глядя на объектив сбоку, вращайте макровинт до тех пор, пока объектив не окажется на расстоянии 1-2 мм от объекта исследования. Делайте это осторожно, чтобы не раздавить микропрепарат.
- Глядя в окуляр (в окуляр смотрите одним глазом, не зажмуривая и не закрывая другой глаз), поднимайте тубус очень медленно, вращая макровинт до тех пор, пока не появится четкое изображение изучаемого объекта.
- Если изображение не появилось, то надо повторить все операции пунктов 4, 5, 6, 7.
3. Лабораторная работа
1) Приготовление препарата кожицы лука.
Из чешуйки лука снять пинцетом часть эпидермиса и положить в каплю окрашенной воды на предметное стекло. Расправить препарат иглой и накрыть покровным стеклом. Рассмотреть приготовленный препарат, зарисовать.

Вопрос: Какие клеточные структуры вы наблюдали?
2) Приготовление препарата среза клубня картофеля
Со среза картофеля соскоблить препаровальной иглой немного мякоти. Поместить ее на предметное стекло в каплю воды, окрашенную слабым раствором йода. Накрыть покровным стеклом. Найти зерна запасного крахмала, зарисоватьих.
Вопрос: Каково значение клеточных включений в жизни организма?
3) Рассматривание под микроскопом готовых микропрепаратов костной и мышечной ткани, мазка крови человека и лягушки. Сравнить эритроциты лягушки и человека, зарисовать.

Гладкая мышечная ткань.
|
Кровь человека |
Кровь лягушки |
4. Вывод:
Клетка является универсальной ячейкой жизни .
| Признаки | Растения | Животные |
| Клеточная стенка | + целлюлоза | - |
| Пластиды | + | - |
| Вакуоли | + | - |
| Запасное вещество | крахмал | гликоген |
5. Закрепление
Выбрать один правильный ответ.
1. Как называются бесцветные пластиды?
А) хлоропласты
Б) лейкопласты
В) рибосомы
Г) хромопласты
2. Какая часть клетки несет в себе наследственную информацию?
А) клеточная оболочка
Б) вакуоль
В) ядро
Г) цитоплазма
3. Как называется часть клетки, придающая ей форму и защищающая ее содержимое?
А) цитоплазма
Б) вакуоль
В) ядерная оболочка
Г) клеточная оболочка
6. Рефлексия
- Что мы сегодня узнали?
- Чему научились?